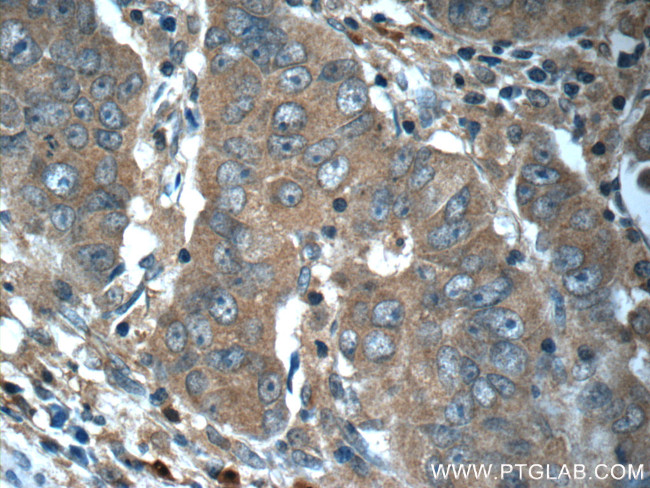
RAF1 Antibody in Immunohistochemistry (Paraffin) (IHC (P))

Search
Proteintech
RAF1 Polyclonal Antibody
{{$productOrderCtrl.translations['antibody.pdp.commerceCard.promotion.promotions']}}
{{$productOrderCtrl.translations['antibody.pdp.commerceCard.promotion.viewpromo']}}
{{$productOrderCtrl.translations['antibody.pdp.commerceCard.promotion.promocode']}}: {{promo.promoCode}} {{promo.promoTitle}} {{promo.promoDescription}}. {{$productOrderCtrl.translations['antibody.pdp.commerceCard.promotion.learnmore']}}
产品信息
51140-1-AP
已发表种属
宿主/亚型
分类
类型
抗原
偶联物
形式
浓度
规格
保存条件
运输条件
靶标信息
Raf-1 (c-Raf) is a MAP kinase kinase kinase (MAP3K) which functions downstream of the Ras family of membrane associated GTPases to which it binds directly. Once activated Raf-1 can phosphorylate to activate the dual specificity protein kinases MEK1 and MEK2 which in turn phosphorylate to activate the serine/threonine specific protein kinases ERK1 and ERK2. Activated ERKs are pleiotropic effectors of cell physiology and play an important role in the control of gene expression involved in the cell division cycle, apoptosis, cell differentiation and cell migration. Mutations in this gene are associated with Noonan syndrome 5 and LEOPARD syndrome 2.
仅用于科研。不用于诊断过程。未经明确授权不得转售。